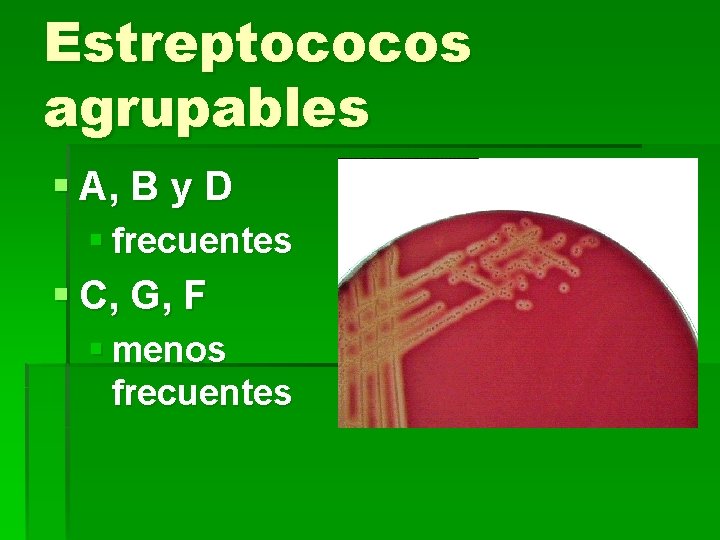
Estreptococos agrupables § A, B y D § frecuentes § C, G, F §
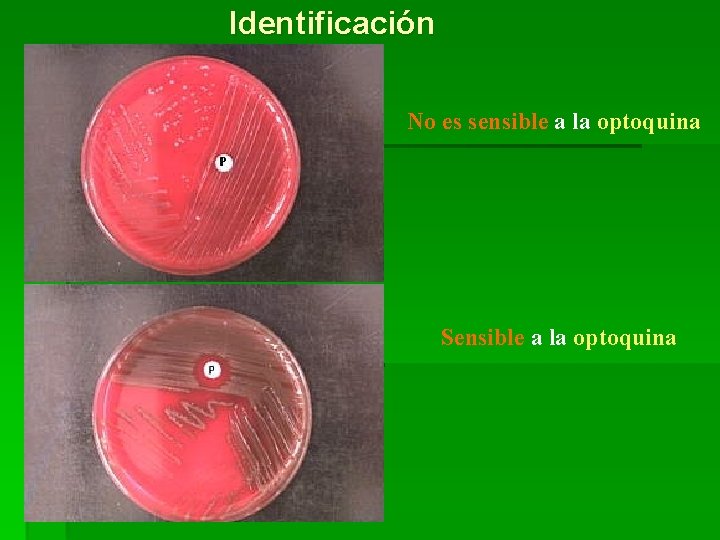
Identificación No es sensible a la optoquina Sensible a la optoquina

Streptococcus spp M Paz UMG2011 Streptococcus spp Gr































































- Slides: 63

Streptococcus spp M. Paz UMG-2011

Streptococcus spp Gr. streptos = bobina, retorcido § § § Anaerobios facultativos Cocos Gram (+) en cadenas y en parejas Catalasa (-) Hemólisis: alfa, beta o gamma Están subdivididos en “grupos” según sus antígenos de superficie § carbohidratos § Los grupos contienen una variedad de “tipos” § proteínas

Streptococcus en cadenas (Tinción de Gram)

Estreptococos: morfología § § § In vitro: cocos en cadenas In vivo: diplococos La longitud de las cadenas tiende a ser inversa a la adecuación del medio. § Lesiones activas en tejidos: diplococos o cocos aislados § Exudados purulentos de lesiones abiertas y medios artificiales: cadenas

Cápsulas y morfología colonial § Muchos producen cápsulas § Grupo “A”: ácido hialurónico § Colonia § Mucoide § Cepas que producen cápsulas grandes § Abundante gel de AH: brillantes y acuosas § Mate § Colonias más planas, más rugosas (deshidratadas) § Brillante § Más pequeñas (NO hialuronidato)

Grupos de Lancefield Rebecca Craighill Lancefield (1895 -1981)

Grupos de Lancefield § Estreptococos beta-hemolíticos § Divididos en grupos inmunológicos por sus antígenos de pared celular o de la cápsula (estreptococos del grupo B): carbohidratos § 20 grupos: A-H y K-V § Algunas especies no son agrupables § Algunas especies pertenecen a varios grupos y un grupo puede tener diferentes especies
Estreptococos agrupables § A, B y D § frecuentes § C, G, F § menos frecuentes

No-agrupables § S. pneumoniae § neumonía § Streptococcus viridans § e. g. S. mutans * Caries dental

Clases hemolíticas § ß- hemolíticos: (S. pyogenes y grupo B) § Amplia zona de hemólisis completa § α- hemolíticos: grupo viridans § Zona más angosta de hemólisis § Decoloración verde § γ – hemolíticos: (S. faecalis) § No hemólisis

Reacción de hemólisis en ASC Beta-hemólisis Colonias blancas Alfa-hemólisis

Streptococcus pyogenes Patogenia § Especie más importante en el hombre § Causa tradicional de la faringitis supurativa no invasiva y de impétigo en la piel § Fiebre reumática § Bacteremia invasiva § Síndrome parecido al Shock tóxico § Fasceítis necrotizante (bacterias comedoras de carne) § Afecta todas las edades con un pico de incidencia entre 5 y 15 años.

Patogénesis § Adhesinas: § Presentes en las fimbrias en la parte externa de la pared celular. § Adhesión al epitelio respiratorio vía fibronectina § Factor F (proteína de unión a la fibronectina) § Ácido lipoteicoico/Proteína F § Evasión de la fagocitosis: Proteína M § Se une al fibrinógeno y bloquea la unión del complemento al peptidoglicano § Cápsula tiene actividad antifagocítica § Colonias mucoides

Factores de Virulencia § Estreptolisina O y S § Estreptolisina O § Destruida por el oxígeno atmosférico § Demostrable solamente en colonias profundas § Estreptolisina S § Estable al oxígeno § Responsable de la hemólisis superficial de la colonia § § Toxina Pirogénica (fiebre escarlatina) Estreptoquinasa § activa plasminógeno § digiere fibrina y otras proteínas § Hialuronidasa § rompe el AH del tejido conectivo § Estreptodornasa § depolimeriza el ADN

Faringitis supurativa § Faringoamigdalitis § Síntomas comunes: § § § § Dolor al tragar Amigdalitis Fiebre alta Dolor de cabeza Náusea Vómitos Malestar General Rinorrea

Fiebre escarlatina • erupción en la piel • toxina eritrogénica

Síntomas de escarlatina § Dolor de garganta § Fiebre, cefalea, escalofríos § Vómitos § Erupción en el cuello y en el tórax, sensación de aspereza, como de "papel de lija" en la piel § Dolor abdominal y muscular. § Desprendimiento de piel en puntas de los dedos de las manos, de los pies y en la ingle § Enrojecimiento e hinchazón de la lengua (lengua de fresa) § Líneas de Pastia (coloración roja intensa en los pliegues que se encuentran en la axila y en la ingle)

Toxina pirogénica • Superantígeno • Mitógeno de linfocitos T • Activa el Sistema inmune

Estreptococia no-supurativa § Fiebre reumática § Enfermedad inflamatoria § Grave § Secuelas crónicas • fiebre • corazón • articulaciones

Fiebre Reumática: etiología • Proteína M – Hace reacción cruzada con la miosina cardíaca – autoinmunidad • Antígenos de la pared celular • – – Pobremente digeridos in vivo Persisten indefinidamente Complejos inmunes se depositan en la articulación.

Glomerulonefritis § Depósitos de Complejos Inmunes en el glomérulo renal § Causa: persistencia de antígenos estreptocócicos § Infección orofaríngea asintomática § Portador

S. pyogenes Ácido lipoteicoico Proteína F fibronectina Células epiteliales

Proteína M INMUNE Complemento Ig. G r r Proteína M r NO-INMUNE péptido-glicano fibrinógeno r r r

§ Papel en el síndrome de shock tóxico estreptocócico § Proteína M formaría agregados enormes en la sangre y tejidos debido a su habilidad para unirse al fibrinógeno. § Los agregados fibrinógeno-proteína M se unen a las integrinas en la superficie de los PMNs y plaquetas. § Activación de las células y la liberación de metabolitos tóxicos y enzimas proteolíticas y glicolíticas. § Si esto ocurre cuando los polimorfonucleares aun no han abandonado el torrente circulatorio, el daño se produce en las células endoteliales dando lugar a los cambios que caracterizan el síndrome del shock tóxico estreptocócico.


Proteína M § Principal blanco § Inmunidad natural § Variación de cepas § antigenicidad § re-infección § ocurre con cepas diferentes

Fasceítis necrotizante § Infecciones necrotizantes o gangrenosas, de etiología típicamente poli-bacteriana § (Gangrena de Meleney) § Producen necrosis masiva de la fascia subcutánea con erosión de los tejidos subdérmicos § Cuadro patológico que se acompaña de extrema toxicidad.

Fasceítis necrotizante § Celulitis: Sólo la piel (y en parte menor el tejido subcutáneo) aparece afectada por la infección. § Típicamente monomicrobianas (estreptococos aeróbicos, otros cocos Gram positivos, bacilos coliformes aeróbicos y clostridios). § Tratamiento: dosis altas de penicilina. § En ocasiones se justifica la incisión de la piel con el objeto de disminuir tensión y prevenir la necrosis, pero el desbridamiento radical generalmente no es necesario.

Fasceítis necrotizante § Etiología: polimicrobiana. § Infección muy agresiva con destrucción del tejido subcutáneo. § En los últimos 10 -12 años se registran, en diversos países, severas infecciones necrotizantes causada por cepas ultravirulentas del estreptococo A, a la que se ha denominado "la bacteria devoradora de rostros" o la "bacteria come-carne". § Mortalidad: 30%.



DIAGNÓSTICO § § § Clínico Microbiológico Serológico (Inmunológico) Serotipificación del aislamiento Secuenciación genética

Aislamiento e identificación § Colonias beta-hemolíticas § crecimiento inhibido por la bacitracina (Taxo A) § Colonias beta-hemolíticas § Detección del antígeno del grupo A

Cultivo de orofaringe

Cultivo de orofaringe


Test Moderno y rápido “Strep” Test Hisopo de garganta (+/- antígeno de estreptococo) - + Anticuerpo Liposoma Antígeno de estreptococo

Diagnóstico Post-infeccioso (serología) § Presencia de anticuerpos a estreptolisina O (ASO) § Importante para determinar si hay secuelas clínicas

Serotipificación Tradicionalmente: Tipificación de proteínas: - M - T - R Actualmente: - Secuenciación del gen de proteína M

Estreptococo del grupo B Streptococcus agalactiae § § Meningitis neonatal Septicemia Fiebre puerperal Transmisión § microbiota vaginal § Síntomas § distrés respiratorio § Apnea § Taquipnea § Neumonía § Shock § Diagnóstico: § Beta-hemólisis § Hidrólisis del hipurato § Reacción de CAMP § Los estreptococos del grupo B producen un factor que aumenta la beta hemólisis de una cepa indicadora de S. aureus


PRUEBA DE CAMP POSITIVA PRUEBA DE CAMP NEGATIVA

Estreptococo del Grupo B - hidrólisis del hipurato

Enterococos § § § Relación distante con otros estreptococos género Enterococcus Microbiota intestinal § Infección del tracto urinario § Contaminación fecal § Infecciones oportunistas § endocarditis § más común E. (S. ) faecalis

Estreptococos del grupo D § Crecimiento en agar bilis-esculina § Precipitado negro § Crecimiento en 6. 5% salina § enterococos § no crecimiento § no-enterococos

Estrep de colonias diminutas: S. anginosus y S. milleri Varios grupos/hemólisis – genéticamente distintos * de las colonias grandes (e. g. S. pyogenes) – no provocan fiebre reumática Colonia grande Colonia diminuta

Estreptococos Viridans § § Diversas especies Infección oral Caries dental Alfa-hemólisis y negativos para otras pruebas § No agrupables § Incluye a S. mutans § Endocarditis § Extracción dental


Prueba de catalasa + -

S. pneumoniae

Streptococcus pneumoniae (neumococos)

Streptococcus pneumoniae § Causa más común de neumonías en jóvenes y adultos: neumococo § Diplococos Gram (+), lanceolados. § Diagnóstico por tinción directa o detección del antígeno capsular en esputo. § Crece bien en agar sangre. § Neumolisina (alfa-hemólisis) § Degrada los eritrocitos en condiciones aeróbicas

S. pneumoniae: patogenia § § Neumonía Otitis media Bacteremia Meningitis § Tasa de mortalidad en adultos hospitalizados: 14%

S. pneumoniae: pacientes a riesgo § Transmisión por vía aérea. Las bacterias son aerosolizadas a partir de tos y estornudos. Puede ser inhalado e iniciar una infección activa. § Ancianos § Niños menores de 2 años § Niños cuidados en guarderías § Pacientes con infección por VIH o anemia falciforme

S. pneumoniae Autolisina: se identifica por su solubilidad en bilis. § Una autolisina (enzima que degrada el peptidoglicano) es liberada por acción de la bilis sobre la pared celular y se une a un ácido teicoico que contiene colina unido al peptidoglicano § La autolisina digiere la pared celular, resultando en la lisis bacteriana. § Si las células son cultivadas con etanolamina en lugar de colina, la etanolamina es incorporada al ácido teicoico y la autolisina no puede lisar la pared celular. Susceptibilidad al Taxo P § S. pneumoniae es susceptible a la optoquina (etilhidrocupreína)

Autólisis - identificación autolisina Ácido teicoico -colina peptidoglicano membrana celular Ácido lipoteicoico Bilis

Prueba de solubilidad en bilis
Identificación No es sensible a la optoquina Sensible a la optoquina

S. pneumoniae Cápsula § Es altamente prominente en cepas virulentas y sus antígenos de carbohidrato varían en estructura entre las cepas. § La cápsula es antifagocítica y la inmunización es primariamente contra la cápsula. § Al usar antisueros tipo-específicos, la cápsula de bacterias aisladas pueden ser fijadas y se hacen visibles microscópicamente: REACCIÓN DE QUELLUNG

Hinchamiento de la cápsula: Quellung

Patogenesis § Activa el complemento por su ácido teicoico. – Grandes números de células inflamatorias en el sitio de infección.

Tratamiento • S. pneumoniae – la mayoría de cepas son susceptibles a la penicilina, aunque la resistencia es también común
